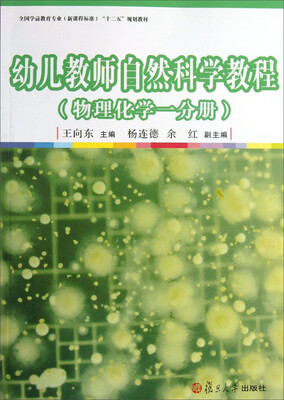
幼儿教师自然科学教程（物理化学一分册）/全国学前教育专业（新课程标准）“十二五”规划教材

Новая женская сменная акриловая сумка-цепочка с ремешком, съемный кошелек, ремни для сумок, аксессуары для сумок через плечо из смолы
Price history chart & currency exchange rate
Customers also viewed

74,829.65 руб.
Commercial furniture dessert shop milk tea shop sofa coffee shop table and chair combination book bar clear bar music restaurant
aliexpress.com
62,801.66 руб.
220V Hot sale full automatic dishwasher 8 Sets freestanding/built-in dishwasher machine for home
aliexpress.com
2,551.84 руб.
Classical Court Maid Character Resins Statue Rockery Artwork Desk Decor Ornaments Figures Sculpture Crafts Vintage Home
aliexpress.com
2,497.67 руб.
10000mAh Magnetic Magsafe Power Bank for Cellphone Fast Charge PD20W QC Wireless Portable Spare Auxiliary Battery PowerBanks
aliexpress.com
3,129.83 руб.
zq Table-Top Solid Wood Photo Frame 7-Inch Picture Frame Decoration Living Room Photos Frame Decoration Home Furnishings
aliexpress.com
817.08 руб.
HB Type-H Rfl BOV Turbocharger Turbo Aluminum Blow Off Valve 25PSI of Boost
aliexpress.com
315.69 руб.
WHO CUTIE Vintage Cat Eye Clear Eye Glasses Frame for Women Transparent Optical Lens Computer Eyeglasses Non Prescription S068
aliexpress.com
564.84 руб.
Happy New Year T Shirt Men Star Wars T-shirt Merry Christmas Tshirt Crew Neck Hoth Sweet Hoth Cotton Adult Tees Free Shipping
aliexpress.com
186.47 руб.
Sasuke Naruto Black Silicone Case Cover for Huawei Honor 8X 8C 8A 8S 10 10i Lite Play V20 Y9 Y7 Y6 Y5 Prime 2018 2019 Back Shell
aliexpress.com
581.09 руб.
Mini Vacuum Sealer Pump Automatic USB Electric Pump with Storage Bags for Clothes Food K888
aliexpress.com
855.77 руб.
Solid Long Dress Women Autumn Winter Sexy Club Party Dress V Neck Stretchy Long Sleeve Sweater White Dresses 2019
aliexpress.com
376.04 руб.
1PC Size S-XL Woman Lady Redu Waist Bust Shaper Shirt Neoprene Slimming Thermo Cami Cinchers
aliexpress.com
95.95 руб.
for Huawei Y7 Prime 2018 / Enjoy 8 Phone Cases 5.99" Slim TPU Cover Marble Printed Silicone Capa for Huawei Nova 2 Lite Shell
aliexpress.com
264.62 руб.
2019 24k Gold Color Bracelets & Bangles for Women Girls Flowers bracelet 19cm Luxury Women Wedding Jewelry
aliexpress.com
2,047.00 руб.
Звездные врата SG 1 круглый ковер из фильма Нескользящий коврик для двери коврик для научной фантастики стул игровой коврик для игровой комнаты спальня детская комната
joom.ru
3,512.47 руб.
cross-border muscle fitness small foot sports pants running fitness trousers men's men's pants
fordeal.com
960.32 руб.
ALLMAX CLA80 Femme, конъюгированная линолевая кислота премиального качества, 1000 мг, 60 мягких таблеток
iherb.com
6,114.97 руб.
NPKDOLL New Toys Silcone Reborn Baby Doll 22 Inch Fashion BeBe Doll Girl Gold Hair Lifelike Baby Children Birthdays Gift Toys
aliexpress.com
1,691.42 руб.
DIY Craft My First Book Montessori Early Education Package Toys Picture Book Handmade Quiet Book DIY Material Kit For Children
aliexpress.com
743.58 руб.
2018 New Bib BBQ Denim painting aprons cowboy Unisex Aprons for Woman Men Cafe Chef barber Kitchen restaurant Cooking WQ051
aliexpress.com![[Jingdong supermarket] Shu Biqi (suitsky) five excellent care baby paper diapers medium M44 [6-11kg]
[Jingdong supermarket] Shu Biqi (suitsky) five excellent care baby paper diapers medium M44 [6-11kg]](http://img20.360buyimg.com/ecps/s400x400_jfs/t6061/313/2960848138/248336/9eb8ebe5/594a50dcN8d97ca57.jpg)
3,167.74 руб.
[Jingdong supermarket] Shu Biqi (suitsky) five excellent care baby paper diapers medium M44 [6-11kg]
joybuy.com
4,110.95 руб.
22pcs/set Outdoor Camping Cookwcare Sets Pots Pans Pots Cups Spoons Forks Picnic Tools
aliexpress.com
257.64 руб.
Fagger FAGOR Anna Soup Pot Set Суп-суп-суп (16 см суп + ложка) Импорт 304 Набор из нержавеющей стали
jd.ru
12.29 руб.
Зелёный шарнир (UGREEN) закрытый замок двери против столкновения дверь немагнитная резина 3M прочная клейкая дверь, чтобы избежать пробивки дверной двери вверх креативная дверь окна всасывание всасывания две загруженные 30365
jd.ru
31.90 руб.
HALO Младенческая спальная сумка Чистый хлопок Пакет Smashing Sleeping Bag S Cowboy Blue
jd.ru
2,907.76 руб.
New Product 3MP HD Full 1920P Security Camera Gray Metal Bullet CCTV AHD Surveillance Camera Waterproof infrared Night Vision
aliexpress.com
1,860.10 руб.
Asecam HD 720P CCTV Infrared 48V POE IP Camera gray Bullet Metal Waterproof Outdoor Onvif WebCam Security Surveillance p2p
aliexpress.com
6,190.02 руб.
creative gifts foldable portable paper stool novelty chair round seat ottoman home furniture
aliexpress.com